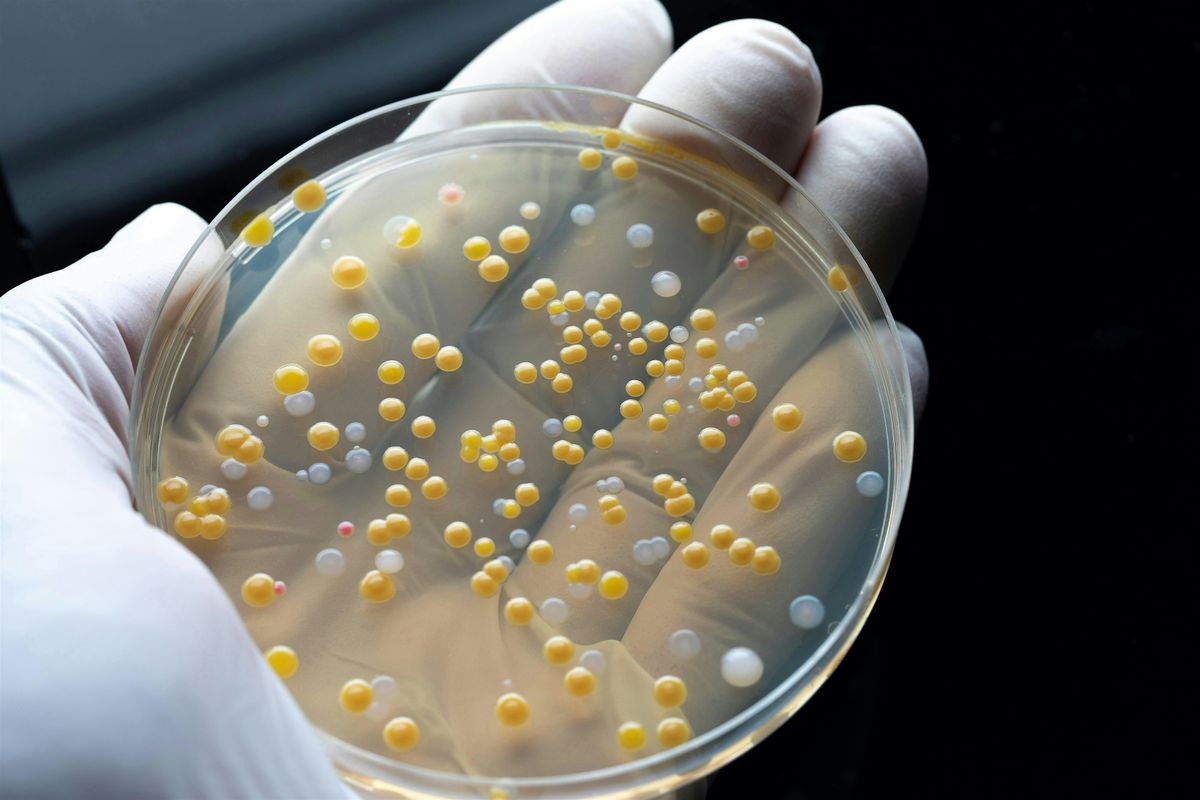

About this Event
Enter the Microscopic World with UM experts seeking tiny solutions to huge challenges in viral defense, antibiotic resistance and environmental contamination. Join the discussion with UM Knowledge Exchange, live at Degree’s Diner and online livestream, Wednesday, March 25, 7pm-8:30pm (CDT).
Moderator: Marike Palmer, Department of Microbiology
Panelists: Peter Pelka, Department of Microbiology; Ned Budisa, Canada Research Chair in Chemical Synthetic Biology, Department of Chemistry; Aleeza Gerstein, Department of Statistics and Microbiology; Ayush Kumar, Associate Dean (Strategic Initiatives), Department of Microbiology

Event Venue & Nearby Stays
Degrees Diner, 65 Chancellors Circle, Winnipeg, Canada
CAD 0.00










